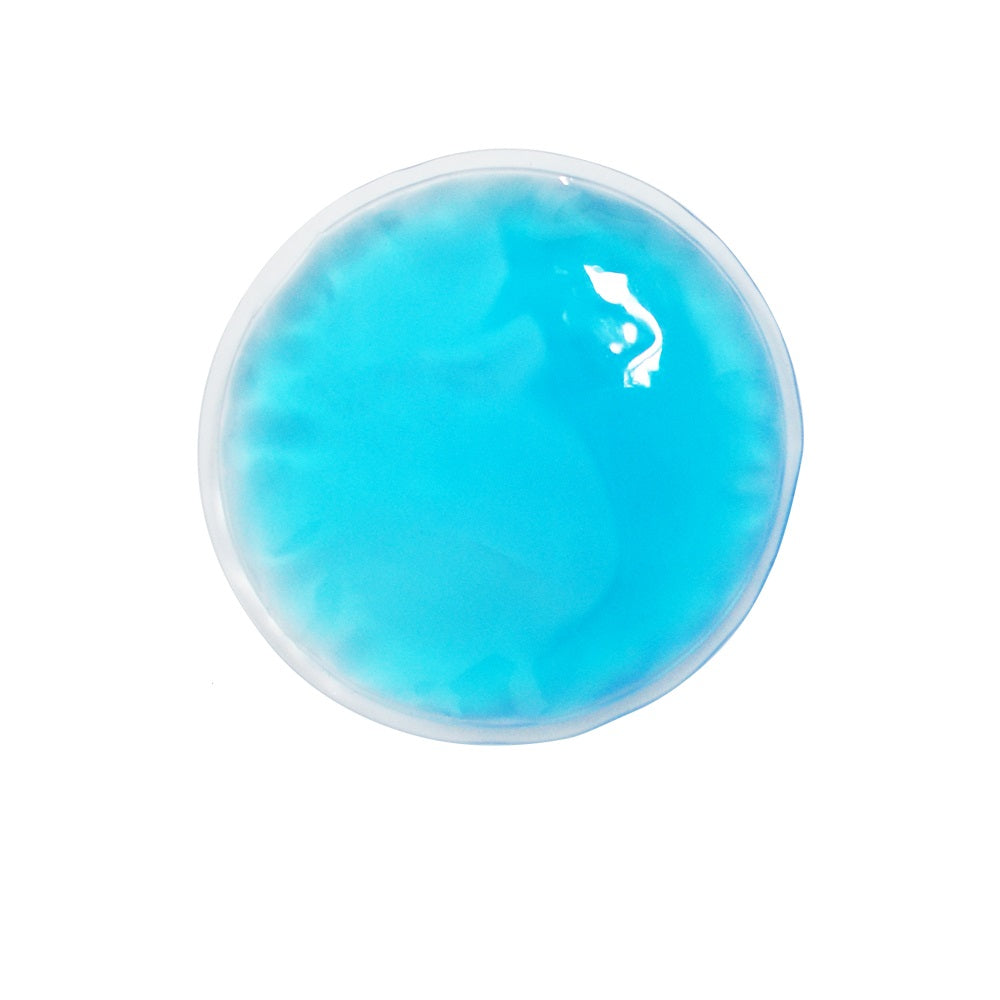

Rezervă gel
Rezervă gel
Preț obișnuit
24,99 lei
Preț obișnuit
Preț redus
24,99 lei
Preț unitar
pe
Livrarea
Livrarea
Livrearea se efectuează prin curier, la adresă, în 2 zile lucrătoare din momentul procesării comenzii.
Plata
Plata
Se face numerar în momentul primirii coletului.
Asistență telefonică
Asistență telefonică
0755 740 727
Luni - Vineri - 09:00 - 17:00
Rezervă gel - Centura Termică Anticolici
Instrucțiuni de încălzire
- Încălzirea gelului în cuptorul cu microunde se face la o putere medie/minimă (400-600w), pentru maxim 5 secunde;
- Încălzirea în apă încălzită (nu clocotită), se face așezând gelul în apă pentru 5-10 secunde, după ce focul a fost oprit;
- Testați temperatura pe propria piele înainte de a aplica centura pentru a nu crea disconfort;
Urmând instrucțiunile de mai sus, gelul se poate reîncălzi ori de câte ori este nevoie.